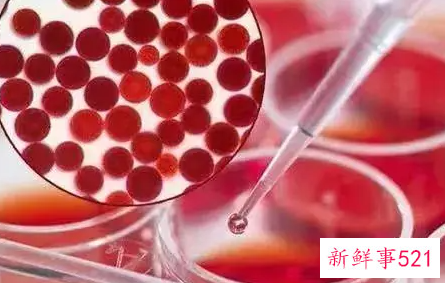
紫外线过敏后如何修复只需三步即可

微信扫码关注紫外线过敏后如何修复只需三步即可
紫外线过敏后如何修复只需三步即可,夏季紫外线比较强,有的人皮肤比较脆弱很容易就过敏,那么如果出现紫外线过敏要怎么修复呢?下面分享紫外线过敏后如何修复只需三步即可,助你对抗紫外线。
一、做足防晒保护
人体长期处于太阳下,很容易引发体内的光变态性反应,这是由于体内的光感物质和紫外线发生了相关作用。对于皮肤敏感的人来说,就会导致紫外线过敏,从而皮肤出现瘙痒。解决这一问题的最佳方法,就是提前做好防晒工作,比如涂抹防晒霜;着装上也尽量选择具有防晒的材质的衣服,这样可以有效阻挡紫外线的照射。

二、食用富含维生素A的食物
紫外线过敏的另一个原因就是体内某些微量元素的缺乏,尤其是维生素A。如果大家紫外线过敏后导致皮肤出现红疹时,建议食用一些富含维生素A的食物,来缓解瘙痒这一症状。可以服用的食物包括苹果、胡萝卜等;也可以服用保健品葡萄籽等,这样不仅可以抗氧化、防过敏,还具有美白皮肤的作用。

三、提前服用抗敏药物
抗敏药物一般是推荐给长时间暴露在阳光下的人群使用的,比如说外景拍摄、海滩嬉戏等。因为这些场合通常很少能找到阴凉的地方,这样大家就会一直被紫外线照射;如果提早服用相关药物后,可以有效避免紫外线过敏。即便出现瘙痒症状,由于体内含有抗敏药物的成分,也可以适时的进行止痒。
除了以上三个方法,紫外线过敏后,大家也可以使用一些止痒药膏,比如比较流行的青草膏、百草膏等,这些药膏中含有薄荷等草本植物,涂抹在瘙痒部位,可以有一丝微凉感,也能够有效止痒。不过还是建议大家平时里注重皮肤的水分,防止皮肤变干,这样也可以减少紫外线过敏的可能性;同时大家也要多多锻炼,增强自身免疫力,这样也能够起到一定的抗敏效果。
一、使用修复的产品
由于紫外线过敏的时候会上肌肤不同程度的泛红,且这个阶段肌肤相对的比较的敏感和脆弱。此时使用修复的产品能够暂时舒缓肌肤的舒适,之后将修复的成分渗透进去之后会帮助肌肤修复和增加肌肤屏障的抵抗力,持续使用朵嘉浓修复乳可以修复,每天3次。
二、清洁肌肤要注意
当肌肤出现紫外线过敏的时候需要修复,但是清洁工作同样的需要注意,只有清洁好之后才能促进后期修复的成功,也能帮助肌肤增加现在的循环。
这个时候清洁肌肤建议不要使用清洁力度过强和碱性程度比较高的产品,所以建议比较温和且能够满足一般的要求即可,适当的时候可以使用敏感肌肤使用的`也是可以的。

三、不要用手抓肌肤
当肌肤出现这种过敏问题的时候会伴随这一定的瘙痒,对于这种现象很多人会忍不住的想用手去抓,因此会不自觉的就用手去抓并且会感觉比较的过瘾。
但是经常的用手抓会使的肌肤产生的过敏毒素越来越多,因此也就会出现抓的越多肌肤越感觉不舒适的问题。这是建议减少用手抓可以选择冰块冷敷降低肌肤的敏感,这样会更加有利于肌肤的修复工作进行。
四、使用含抗过敏的护肤品
虽然肌肤已经出现过敏问题需要修复,但是想要快速的修复还是需要使用增加肌肤抗过敏的护肤品,这样肌肤能够抵抗外界刺激的同时增加自我的修复能力。
五、减少化妆或尽量不化妆
现在的女生出门不化妆就会感觉比较的自卑,但是在肌肤出现紫外线过敏之后是不建议化妆的,使用化妆品会让其中的某次成分刺激到肌肤并有可能增加过敏的现象,所以建议日常生活中尽量的不要化妆。
如果想要化妆的话建议选用不含光感物质较多和吸收紫外线比较多的产品,并注意回来之后要温和的卸妆并做后期的修复工作才可。
六、日常的习惯和保养也要重视
注意日常的生活的习惯和保养方式是辅助过敏修复成功的关键,建议外出的时候要做做到全副武装来减少肌肤接触紫外线,可以佩戴帽子。
推荐阅读
一起来调教小母狗吧
机缘巧合之下结识了这只小母狗,母狗166-45kg,除了屁股都已经开发完毕,最近突发想法,想找一对情侣或者夫妻同房不换或者女狼加入一起调教,费用AA(单女免),不考虑普通快捷酒店,位置0510附近。另,大家的评论母狗都会
2026-03-05
春节期间遇到的极品母狗
春节期间无意见遇到的极品母狗,21岁,身材绝了。可惜距离有点远,不然勾我心魄者必操之。跟小骚货约好了,把她的照片发到论坛上,想看大家会怎么点评她的身材。欢迎踊跃调教。1. 年龄212. 被几个人操过43. 是否喜欢露出,
2026-03-05
分享朋友前任的几张自拍
分享朋友前任的几张自拍
2026-03-05
瑜伽裤健身
健身着装向来是个颇具争议的话题。有人称赞其专业,有人指责其暴露。实际上,瑜伽裤实用性极强,抖音“瑜伽裤健身”的播放量超120亿次。超八成女会员选择它,是因其弹性佳,运动时既不勒也不滑。教练也表示,穿着瑜伽
2026-03-05
很多女生在相亲择偶中把握不住机会?
为什么很多女生在相亲择偶中遇到优质男把握不住机会?前几天朋友给我讲了一个。她在电视台生活频道,组织相亲大会嘛,一个33的女的看上一个30的男的。外形都不错,俩人一聊,一个公务员一个事业编。女的问男的:有车有
2026-03-05
推荐文章